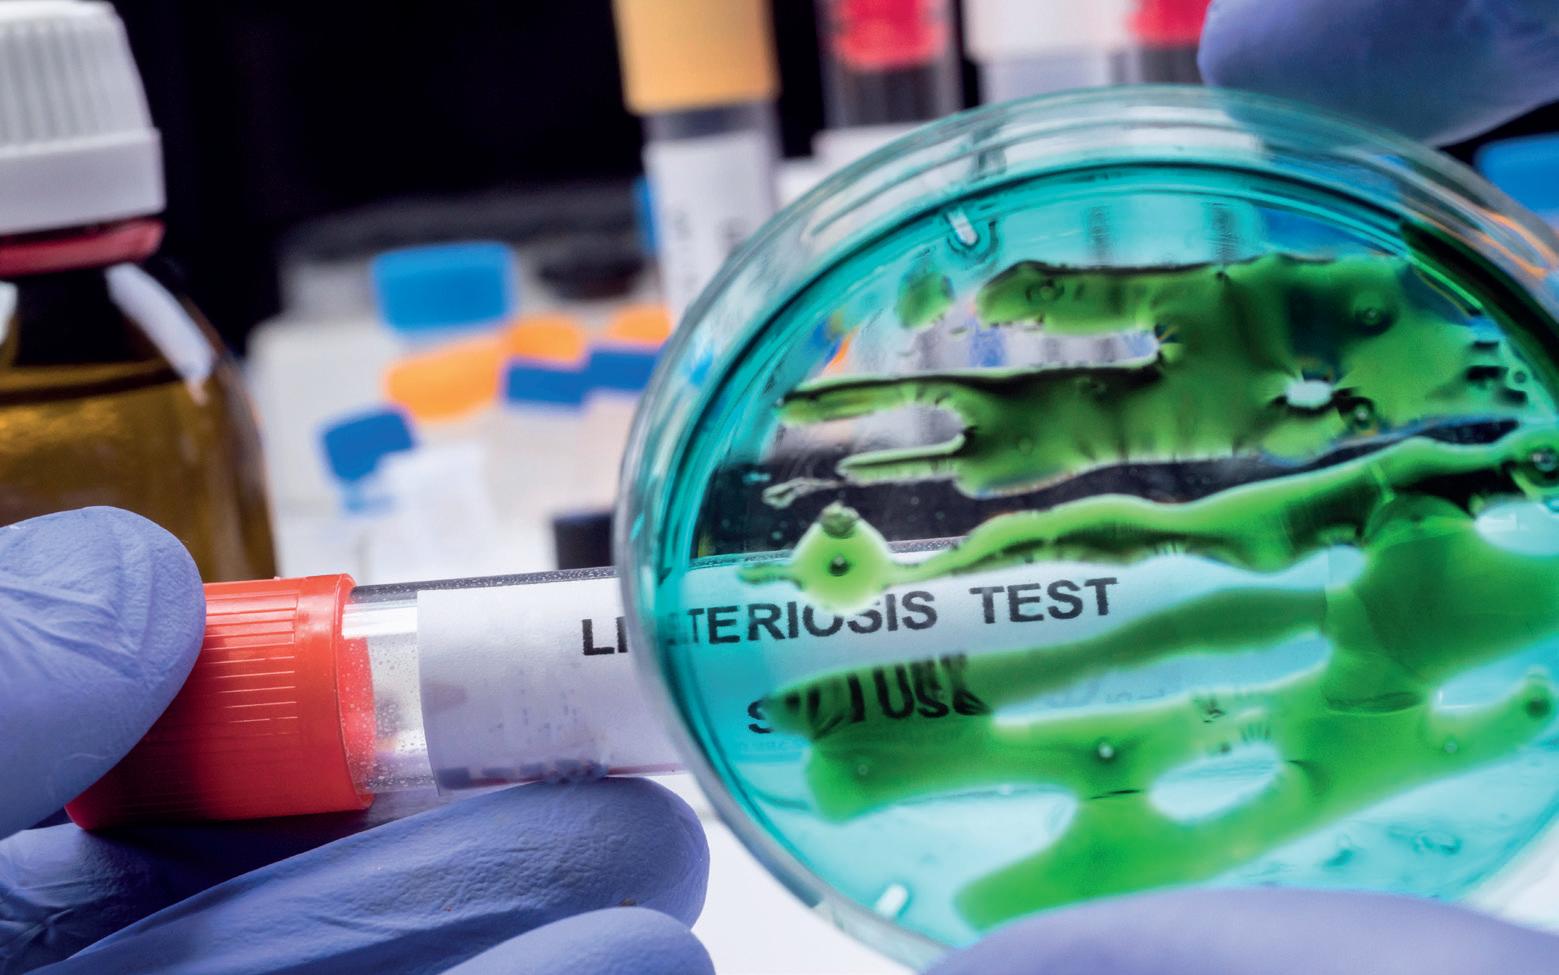

SCHONE SCHIJN
Een innovatie is iets - een product, proces, dienst of denkwijze - dat vernieuwend is én baanbrekend, grensverleggend. Die weg gaat niet altijd over rozen.
Niet ieder briljant idee schopt het tot een innovatie. En niet iedere innovatie wordt uiteindelijk baanbrekend. In het tijdschrift De Ingenieur (maart 2024) las ik een artikel over de startup Sponsh. Ondanks een flitsende start, vele tonnen aan investeringen en miljoenen aan toezeggingen, lukte het niet de techniek die ze hadden bedacht werkend te krijgen. ‘Hoe een startupdroom als een zeepbel uiteenspatte’ is het openhartige verslag van een de oprichters. Aan het eind geeft hij in vijf bulletpoints weer wat hij van deze reis heeft geleerd. Het vijfde en laatste luidt: ‘Met eerlijke verhalen kom je een heel eind’.
Een beetje jaloers was ik wel op het blad. Niet veel mensen zijn bereid om écht het eerlijke verhaal te delen over het pad dat ze hebben bewandeld, dus inclusief de zoektocht, de struikelblokken, knelpunten en valkuilen die ze onderweg tegenkwamen. We worden er met z’n allen ook niet beter in: op social media is zo’n beetje alles schone schijn. Scrollend door FB, Insta en LinkedIn lacht de wereld van anderen mij schijnbaar briljant en vlekkeloos tegemoet. En ach; als het in werkelijkheid wat minder mooi blijkt, dan gooien we er toch gewoon een filter overheen? Of we bewerken de situatie met een laagje AI. Wie gaat er nou toegeven wat en waar het bij jou (of jouw bedrijf) misging en wat je daarvan hebt geleerd? Nee, dat doe je niet in het openbaar.
Toch wel, zo ontdekte ik onlangs. Ooit gehoord van ‘Het Instituut voor Briljante Mislukkingen’? Dat initiatief omarmt de leerzame waarde van mislukkingen, met als doel een cultuur van openheid en leren van mislukkingen te bevorderen. Ze hebben zelfs een Award in het leven geroepen. Wat een verademing!
Innoveren is onlosmakelijk verbonden met veranderen; iedereen met een beetje levenservaring weet hoe moeilijk dat is. Veranderen draait om leren; en leren gaat met vallen en opstaan. Niet één keer, maar keer op keer. De volgende editie gaat over voedselveiligheid. Wie durft zijn eerlijke verhaal met ons te delen?
Judith Witte judith@vakbladvoedingsindustrie.nl

Van de hoofdredacteur




































 door Saskia Stender
door Saskia Stender
OSV OP FOOD TECH EVENT
WOENSDAG 15 EN DONDERDAG 16 MEI 2024, ’S-HERTOGENBOSCH

Het is je vast niet ontgaan: tijdens het Food Tech Event in de Brabanthallen in ’s-Hertogenbosch staan we samen met 21 OSV-leden. We bezetten met zijn allen een kwart van de beursvloer. Daar zijn we best trots op.
Mede door onze deelname is de focus van de beurs verandert. Het gaat niet meer alleen over technologie. Een foodproducent kan zich nu volledig laten informeren van vloer en wanden tot automatisering, en van productielijn tot desinfectie. One-stop shopping. Dat was iets wat we misten in Nederland.
DEZE OSV-LEDEN DOEN ALLEMAAL MEE:
Aptean; Bakker machinebouw; CSB System Benelux ; DNA Services; DRT Vloeren ; Equans Refrigeration; Fresh Quality Support; GEA Food; Handtmann Benelux ; HAP BV ; Jackit; Jansen Techniek; Parts on
Demand; Richmond/Elitech; Ruys Groep; Scharff Techniek; Simpel Desinfecteren; Spako Food Machinery; Staubli Robotics; VIRO Group en vakblad Voedingsindustrie/OSV.
We nodigen al onze leden en lezers van harte uit om ons te bezoeken, een goed gesprek aan te gaan in onze lounge, de demopleinen te bezichtigen en deel te nemen aan diverse presentaties die we op dit deel van de beursvloer houden. Van 3D printing tot uitdieping van AI in food. Achterin deze editie vind je meer informatie over de beurs en een greep uit de standhouders. Wij zijn er helemaal klaar voor. Samen zorgen we voor een waardevolle beurs!
PS: Er is nog 1 OSV-stand beschikbaar in ons deel op de beursvloer. Je kunt nog meeliften op ons succes.
www.OSVnetwerk.com VOEDINGSINDUSTRIE APRIL 2024 6




































































door Matthijs Bremer | Foodbusiness.nl

‘We moeten kritisch naar de footprint van de producten kijken’
Het interview
ARNOLD BURGER:
‘DE MARKT IS KLAAR VOOR HYBRIDE PRODUCTEN’
Enkco, dochteronderneming van Van Loon Group, gaat in samenwerking met Olijck Foods producten leveren die deels bestaan uit vlees en deels uit plantaardige ingrediënten, met een hoofdrol voor zeewier. Commercieel directeur Foodservice van Enkco, Arnold Burger
vertelt waarom hij potentie ziet in een markt voor hybride producten.
Het bedrijf heeft duidelijk vertrouwen in de nieuwe oplossing. Enkco zet meteen in op een hele reeks aan producten, waaronder burgers, balletjes, vinken, kipproducten en carpaccio. Arnold: “Daarnaast zijn er al allerlei producten in ontwikkeling voor de toekomst. Hierbij werken we niet alleen met zeewier, maar gebruiken we ook andere plantaardige grondstoffen.”
Het gevaar bestaat natuurlijk dat de consument hybride vlees als vlees noch vis ziet. Wat is jullie doelgroep?
“Wij maken ons nieuwe product echt voor de vleesliefhebber en flexitariërs, eigenlijk voor iedereen die vlees eet. Voor mij is hybride vlees gewoon een vleesproduct. Er zijn al heel veel producten op de markt waarbij vlees met een ander product wordt vermengd. Denk aan een cordon bleu. Daar zit paneermeel, ham en kaas in, maar dat zien we gewoon als vlees.”
Op welke markten mikken jullie?
“Wij richten ons op de foodservice - catering, zorg- en onderwijsinstellingen - en de maaltijdbereiders. Innovaties beginnen traditioneel bij de foodservice. Als het daar succesvol is gelanceerd, pakt de retail het vaak op. Binnen de foodservice richten wij ons op de consument in Nederland, België en Duitsland.”
Er zijn eerder hybride producten op de markt geweest, maar het was nooit een succes. Waarom gaan jullie wel slagen?
“Het klopt dat hybride niet nieuw is. We hebben in 2019 al een concept met het merk Halvom op de markt gebracht. De markt is er, denken wij, nu wel klaar voor. De consument wordt bestookt met klimaatdiscussies én de aanbieder heeft vanuit de overheid verplichtingen voor de duurzaamheidsrapportage CSRD en Scope 3.
Door de nieuwe duurzaamheidsstandaarden zijn grote bedrijven verplicht om kritisch naar de footprint van de producten te kijken. In de basis betekent 25% minder vlees ook dat de CO2-uitstoot, gebruik van zoetwater en verbruik van landbouwgrond met een kwart afneemt. Voor veel mensen is de stap naar 100% plantaardig eten veel te groot. Met kleine stappen, kunnen we ook een grote impact maken.”
“Uit verkoopcijfers blijkt dat consumenten vegetarische alternatieven niet lekker genoeg vinden. Onze nieuwe hybride producten passen prima binnen CSRD-standaarden, en worden ook geaccepteerd door de markt. Op het gebied van smaak hoef je namelijk nauwelijks concessies te doen. Deze hybride producten kunnen zich meten met vleesproducten in termen van smaak, textuur en sappigheid.” >>
VOEDINGSINDUSTRIE APRIL 2024 11
































Hoe is het mogelijk om geen concessies aan smaak te doen als je een deel van het vlees vervangt door een plantaardig product?
“In de producten die we samen met Olijck hebben ontwikkeld, gebruiken we een mix van zeewieren. Het unieke van zeewier is dat dit ervoor zorgt dat de smaak van vleesvetten vast wordt gehouden. Zo blijven de producten sappig. De mix van zeewieren zorgt voor een goede natuurlijke binding, het gebruik van bindingsmiddelen is hierdoor beperkt. Door de toevoeging van zeewier in combinatie met rundvlees en groenten zorgt het voor de ultieme smaakbeleving zoals je die ook heb bij ‘gewoon’ vlees. Je eet dus minder vlees, zonder verlies van smaak, structuur en beleving. Daarnaast zet je grote stappen om je CO uitstoot te reduceren.”
Worden de producten ook goedkoper dan vlees?
“Dat is helaas nu nog niet zo. We gebruiken alleen lokaal zeewier uit de Noordzee. Dat is op het moment nog duurder dan een vleescomponent. Daarom kosten de producten zo’n 10% tot 15% meer. Op termijn gaat hybride vlees mogelijk het prijsniveau van de vleesproducten benaderen, maar daarvoor is nog wel schaalgrootte nodig.”
Is er in de toekomst nog wel een markt voor gehaktproducten als die hybride producten zo goed zijn en straks ook nog eens goedkoper worden?
“Zeker. Het is zeer lastig om de specifieke smaak en voedingswaarde van vlees precies te evenaren. Er blijft altijd een grote groep echte vleesliefhebbers. Gewoontes van mensen veranderen niet zo snel.”
Dit artikel is eerder verschenen op Foodbusiness.nl

VOEDINGSINDUSTRIE APRIL 2024 13
door Judith Witte
‘ECHT INNOVEREN DOE JE SAMEN’
Het innovatieklimaat in Nederland staat onder druk. Dat is de belangrijkste conclusie van de Nederlandse Innovatie Monitor 2023, en de kop van een recente brandbrief die FME – met steun van andere partijen - naar de Kamer stuurde. Veel bedrijven hebben last van macroeconomische verstoringen en stellen investeringen in innovatie uit. Toch zijn er volop kansen. Drie Nederlandse veranderaars aan het woord.
De Nederlandse Innovatie Monitor is één van de grootste jaarlijkse vragenlijstonderzoeken naar innovatie en ondernemerschap onder Nederlandse bedrijven. Het onderzoek wordt uitgevoerd onder leiding van Henk Volberda, hoogleraar Strategie en Innovatie aan de Universiteit van Amsterdam en auteur van tal van boeken over innovatie, ondernemerschap en management. De Monitor meet de mate waarin bedrijven bezig zijn met incrementele verbeteringen in bestaande markten (exploitatieve innovatie), radicale innovaties gericht op nieuwe markten, verkoopkanalen en consumenten (exploratieve innovatie), en nieuwe vormen van organiseren en leidinggeven (managementinnovatie).
“In de vierde industriële revolutie is technologie belangrijk, maar niet de meest doorslaggevende factor voor innovatiesucces,” zo stelt Henk. “Uit ons onderzoek blijkt dat maar liefst driekwart van dat succes bepaald wordt door ándere factoren.” De bepalende elementen van succes vat hij samen in een ‘Schijf van Vijf’. Naast technologische vernieuwing zijn dat leiderschapsstijl, de manier van organiseren, de inrichting van arbeid en de co-creatie. In dit artikel zoomen we in op elk van deze elementen. Dit doen we samen met Arry Verhage en Lisanne van Oosterhoud; beiden veranderaars in hart en nieren, en volop verbonden met de praktijk van de voedingsindustrie.

Arry Verhage is projectleider ‘groene transitie’ bij Aeres MBO in Leeuwarden, voorzitter van de stuurgroep Bakery Sweets Center en Programmadirecteur Strategie van Aeres. Zijn belangrijkste taak als programmadirecteur is het implementeren van de meerjarenstrategie 2023-2027 ‘De Groene Veranderaar’ binnen de hele Aeres-groep. “Mijn doel is mensen uit het onderwijs, bedrijfsleven en overheid mobiliseren om sámen te innoveren. Het gevoel van urgentie is groot, er móet echt wat veranderen. Er zijn grote uitdagingen waar iedereen mee te maken heeft: personeelsproblemen, het klimaat, de eiwit- en de energietransitie. Om deze transities te laten slagen, helpt het als je kennis uitwisselt en samen optrekt.”
Trends & ontwikkelingen
VOEDINGSINDUSTRIE APRIL 2024 14

Lisanne van Oosterhoud is programmamanager van het programmabureau Next Tech Food Factories, de programmatische samenwerking tussen Brainport Development en Agrifood Capital. Het programmabureau ondersteunt bedrijven in hun innovatietrajecten met onder andere innovatievouchers, coaching, training en toegang tot een kennisnetwerk. “Dat doen we door samen te werken met voedselverwerkende bedrijven, hightech leveranciers en machinebouwers. We werken met name aan het ontwikkelen, testen en de implementatie van robotisering, kunstmatige intelligentie en andere slimme technologieën in voedselverwerking.”
DE KNELPUNTEN
Henk: “Uit de Innovatie Monitor blijkt dat driekwart van de bedrijven last heeft van personeelskrapte en een kwart van onvoorspelbare energiekosten. Daarbij komt de hoge inflatie, en de grondstoffencrisis speelt veel bedrijven parten. Daardoor stellen ze langetermijn investeringen voor innovatie uit, terwijl juist radicale innovaties belangrijk zijn voor de ondernemerskracht in het bedrijfsleven. Grotere bedrijven vinden dat de regeldruk toeneemt, het fiscale klimaat minder attractief wordt en de voorspelbaarheid van de overheid afneemt.”
Lisanne: “Ik hoor geregeld dat de administratielast door alle wet- en regelgeving
bedrijven zwaar valt. Dat geldt met name voor het MKB. Omdat ze vaak niet weten waar ze met welke vragen terecht kunnen, zijn ze keer op keer het wiel opnieuw aan het uitvinden. Efficiënt is dat niet.”
Henk: “Dat veel bedrijven regelgeving als een beperking zien, vind ik niet helemaal terecht. Door de nieuwe Europese richtlijn
CSRD (Corporate Sustainability Reporting Directive) zullen in de toekomst steeds meer bedrijven worden afgerekend op hoe duurzaam ze ondernemen. Vooroplopen op dit gebied is op korte termijn misschien een concurrentienadeel, op lange termijn zal het een voordeel zijn. Bovendien blijkt uit onderzoek dat bedrijven die beter scoren
>>
VOEDINGSINDUSTRIE APRIL 2024 15
HYGIËNE ZIT IN DE DETAILS *
*Repak legt de lat hoger dan de NEN-EN 1672-2_2020

www.repaknederland.nl









op duurzaamheid, vaak innovatiever zijn. Kennelijk is het zo dat als je gedwongen wordt om te voldoen aan verscherpte eisen, dat je dwingt om creatiever te zijn en nieuwe technologieën toe te passen.”
Lisanne: “Inderdaad, ook toen de energiekosten fors omhoog gingen, zagen we opeens versnelde innovatie plaatsvinden. Bedrijven werden heel creatief in het vinden van oplossingen om hun energiegebruik te verlagen en beter te sturen op de kosten ervan.”
EÉN: TECHNOLOGISCHE VERNIEUWING
Henk: “Een groot probleem in de Nederlandse industrie is dat onze productiviteit maar marginaal toeneemt. Daarom moeten we investeren in nieuwe technologieën; in het automatiseren en robotiseren van productieprocessen. Maar ook in technici en dataspecialisten. En die zijn er niet genoeg. De productiviteits-paradox is dat organisaties door de zogenaamde J-curve moeten: door te innoveren presteren ze in eerste instantie vaak
slechter. Op de lange termijn plukken ze er wél de vruchten van. Veel bedrijven prioriteren echter kortetermijnwinstgevendheid boven langetermijn-continuïteit.”
Arry: “Toch weten we dat de omstandigheden gaan veranderen. De samenstelling van de arbeidsmarkt, het klimaat, hoe we omgaan met grondstoffen en energie. Deze transities vragen om langetermijninvesteringen.”
Henk: “Voor radicale innovaties geldt: employee first, customer second.”
Lisanne knikt: “Echte innovatie gaat verder dan wat jouw klant wil. We helpen bedrijven daarom om hun innovatievraag helder te krijgen door te achterhalen wat de vraag áchter de vraag is.”
Arry: “Dergelijke vraagstukken kun je goed samen met opleidingen oppakken. Het blijkt heel motiverend te zijn voor studenten om een vraag te krijgen waar niemand nog het antwoord op weet. Anderzijds gaat het in de voedingsindustrie vaak over heel praktische vraagstukken. ‘Als we overstappen van een gasgestookte oven naar een elektrische;
wat betekent dat dan?’ Ook daarin kun je in samenwerking met scholen en studenten goed naar antwoorden zoeken.”
TWEE: DIENEND LEIDERSCHAP
Henk: “Bedrijven denken vaak: ‘als ik maar flink investeer in technologie, komt het wel goed met mijn innovatieve kracht’. Maar om succesvol te zijn, moet je ook aandacht hebben voor de zachte kant van innovatie. Dienend leiderschap noem ik dat. Managers moeten medewerkers de ruimte en ondersteuning geven om te werken aan hun persoonlijke ontwikkeling. Een integrale visie op technologie, cultuur, organisatie én samenwerking is daarbij essentieel; managers moeten in staat zijn de werelden van technologie en management met elkaar te verbinden. Het management moet ook de bereidheid hebben om te investeren in innovatie. Ze zullen vele experimentjes moeten opstarten, en er rekening mee houden dat die niet allemaal succesvol zullen zijn.”
Arry: “Dat is precies waarom het zo interessant is voor bedrijven om samen te werken met het onderwijs! Het kostenplaatje wordt dan echt anders. Kijk naar ons broodpastaproject. Startpunt was de grote hoeveelheid onverkocht brood, jaarlijks zo’n 150.000 ton. Een deel daarvan gaat naar veevoer. De vraag was: is er geen manier te bedenken om dat brood terug in de voedselketen te krijgen? Een van de bakkerijen aangesloten bij Bakery Sweets Center, had de oplossing. Ze hadden samen met een onderzoeksinstituut een proces ontwikkeld om brood middels vergisting te verwerken tot een brood/ suikerpasta; een nieuwe grondstof.”
Een grondstof waarvoor?
Arry: “Juist, dat was de vraag! Ze wisten: ‘We hebben hier iets te pakken,… maar wat?’ De onderzoeker stond letterlijk met twee emmers van deze grondstof voor een groep studenten. ‘We willen dit verwerken,
& ontwikkelingen
Trends
>> VOEDINGSINDUSTRIE APRIL 2024 17
Henk Volberda
Trends & ontwikkelingen

Studenten onderzoeken nu bijvoorbeeld of ze ook glutenvrije broodpasta kunnen maken. En een compleet ander innovatieproject pakt vraagstukken op rondom magnesiumzout als vervanger van gangbaar zout.”
Lisanne ziet gelijk de voordelen: “Ja, mooi! Bedrijven gaan pas investeren in iets nieuws als bewezen is dat ze er ook echt iets aan hebben. Dat voorwerk is hier door de studenten al gedaan. Daarom ook zijn test- en
validatiefaciliteiten een belangrijk onderdeel
Next Tech Food Factories focust op de techniek van automatisering en robotisering. Lisanne, hoe zie jij de rol van ‘dienend
“Wij benadrukken in de trajecten dat technologie een middel is, geen doel op zich,” antwoordt ze. “Het gaat om de uitdagingen die je ermee oplost, welke waarde dit oplevert, voor wie en op welke manier. Hiervoor is het cruciaal de juiste vragen en behoeften naar boven te halen bij de voedselverwerkende bedrijven. En managers moeten de mensen op de werkvloer vanaf het begin meenemen in het veranderproces, en waardering hebben voor de expertise die er al is. Het is daarbij belangrijk je te realiseren dat iedereen op een andere manier leert, dus kijk goed naar de behoeftes van individuele werknemers. Soms zijn ze bang: ‘Gaat het ambachtelijk proces niet verloren als we automatiseren en robotiseren?’ ‘Hou ik mijn baan wel?’ Onze rol is bedrijven te
laten zien wat er mogelijk is; wat de innovatie betekent voor je businesscase én voor je mensen. Een voorbeeld: een bedrijf besloot een cobot aan te schaffen die op verschillende plekken in de fabriek kon worden neergezet, onder andere om zware bakplaten te verplaatsen. De operators stonden in eerste instantie wat argwanend tegenover de knalgele cobot. Door ze goed te begeleiden, zagen ze al snel de voordelen; hun werk werd minder zwaar en belastend. De cobot werd door de operators zelfs liefkozend ‘Tweety’ genoemd. Toen hij op een dag weg moest voor onderhoud, bleek dat ze hem niet meer kwijt wilden.”
DRIE: ORGANISATIEMODELLEN
Henk: “Het derde element uit de Schijf van Vijf gaat over de manier waarop je technologie en leiderschap organiseert. Uit onderzoek blijkt dat bedrijven die platter zijn georganiseerd, makkelijker innoveren. De traditionele functionele hiërarchie leidt tot een statische organisatie; verregaande arbeidsspecialisatie waarbij mensen herhaalde simpele taken doen, weinig betrokken zijn en een lage arbeidsmotivatie hebben. Innovatieve organisaties werken meer met zelforganiserende teams waar mensen geen functies hebben, maar rollen en duidelijke doelstellingen.”
Arry haakt daar graag op in: “Foodproductiebedrijven zijn vaak traditioneel ingericht. Het is voor hen niet makkelijk om de balans te vinden tussen ‘productie draaien met zo min mogelijk fouten en stilstand’, versus ‘we willen dat de medewerker zich hier verantwoordelijk voor voelt en met verbetervoorstellen komt’. In het traject wendbaar vakmanschap (www.wvlo.nl) onderzochten we samen met TNO aan welke knoppen bedrijven kunnen draaien om het leren en het innovatief vermogen van hun organisatie te verbeteren. Een van de conclusies was dat het belangrijk is dat jouw medewerkers autonomie hebben en variatie in hun werk. In de cursus ‘leiding geven aan wendbaar vakmanschap’ leren we leidinggevenden hoe ze hun rol zó kunnen
 ©TON KASTERMANS
©TON KASTERMANS
VOEDINGSINDUSTRIE APRIL 2024 18
Arry Verhage
invullen dat de medewerkers daarin goed worden ondersteund.”
VIER: VAARDIGHEDEN
Henk: “Dat brengt ons bij het vierde element: investeren in vaardigheden. Volgens het Future Jobs onderzoek van World Economic Form zal in 2030 de belangrijkste vaardigheid voor medewerkers ‘creativiteit’ zijn. Alles wat je kan standaardiseren wordt immers overgenomen door een robot, machine of een algoritme. De verwachting is dat we zo’n 44 procent van al onze kernvaardigheden moeten vernieuwen. Daarom moet ook de voedingsindustrie nu inzetten op vaardighedentrajecten om ervoor te zorgen dat hun mensen meekunnen met die veranderingen. Uit ander onderzoek blijkt dat mensen met zogenaamde ‘T-shaped capabilities’ heel creatief zijn. Kennis moet een bepaalde diepte hebben, maar daarnaast heb je ook oppervlakkige kennis nodig van aanpalende kennisgebieden. Om te innoveren moet je in staat zijn om meerdere kennisgebieden te integreren. Ik vind het altijd jammer als ik hoor dat mensen een bepaalde opleiding niet mogen doen omdat die niet direct in het verlengde van hun functie ligt. Een brede kennis is essentieel voor een innovatieve mindset.”
Lisanne: “Wat ook helpt voor een innovatieve mindset: laat jongeren in je bedrijf meedenken over de richting voor de toekomst. Maak gebruik van hun enthousiasme, creativiteit en digitale skills en zorg voor kruisbestuiving met bestaande kennis en expertise. En biedt stages en ontwikkeltrajecten aan; ook voor de eigen medewerkers. Ik merk steeds weer dat in een informele setting meer wordt gedeeld en vrijer wordt gedacht. Dat geldt niet alleen binnen, maar ook tússen bedrijven. Die setting kun je creëren, bijvoorbeeld door samen beurzen te bezoeken of op een andere manier met elkaar op pad te gaan. De informele gesprekken die dan ontstaan bevorderen de samenwerking op lange termijn.”
VIJF: CO-CREATIE
Henk: “Daarmee komen we bij het vijfde en laatste element: co-creatie. Dit betekent dat je samen met andere partners in een ecosysteem gaat innoveren. Kennis gaat delen. Echt innoveren kan je niet alleen. Ook uit onderzoek blijkt dat open innovatie sneller tot succes leidt.”
Arry: “Bakery Sweets Center is daarvan een mooi voorbeeld. Dit is inmiddels een vereniging geworden. Het is ontstaan doordat bakkerij- en zoetwarenbedrijven geen

personeel konden vinden; daarom klopten ze aan bij regionale opleiders: Aeres, Firda en Hogeschool Van Hall Larenstein. Ze vroegen zich ook af of de jongeren op de opleiding wel de dingen leren die zíj belangrijk vinden. Tja, om dat te ontdekken zul je toch met scholen moeten samenwerken. De bedrijven hebben hierin het voortouw genomen. En net als de voetbalclub waar je lidmaatschap betaalt en af en toe bardienst hebt, zetten zij zich in voor de vereniging: er zijn werkgroepen waarin ze actief zijn, onder andere op het gebied van onderzoek en innovatie. Zo krijg je bedrijven mee, voelen ze zich betrokken en worden ze enthousiast. Er zijn afgelopen jaren heel wat van dit soort samenwerkingsverbanden ontstaan binnen de voedingsindustrie (zie ook www.sol-online.nl red.). Mijn oproep: Sluit je aan! Het levert veel op. En je komt in de picture bij jonge, creatieve mensen die na hun studie bij jou kunnen komen werken.”
Lisanne: “Co-creatie is essentieel, maar we merken dat veel bedrijven door de bomen het bos niet meer zien. Ze weten niet waar ze met hun innovatievraag terecht kunnen, er is een enorme versnippering van kennis. Vanuit Next Tech Food Factories proberen we die te bundelen. We zijn innovatietrajecten gestart in onder andere de cobotisering in voedselverwerkende bedrijven, automatisch sorteren en verpakken van fruit, en het real-time monitoren van inhoudsstoffen bij onder andere aadappelverwerking. Ook het bevorderen van de capaciteit van Europese regionale digitale innovatie-ecosystemen voor voedselverwerking staat hoog op onze agenda. Er zijn veel overkoepelende uitdagingen die niet per se morgen opgelost hoeven te worden, maar er wel aankomen. Het is essentieel dat bedrijven zelf een stuk eigenaarschap voelen voor de oplossingen. Dat lukt alleen door écht naar elkaar te luisteren en te leren van elkaar; op basis van samenwerking en vertrouwen. Dat blijkt nog wel lastig overigens: veel foodbedrijven zijn dat niet gewend. En er is grote concurrentie. Maar als die vertrouwensband eenmaal is opgebouwd, willen ze echt wel.” n
©SANDRA PEERENBOOM
VOEDINGSINDUSTRIE APRIL 2024 19
Lisanne van Oosterhoud
door Janneke Vermeulen
INNOVATIE IN DE CHOCOLADEDECORATIE
Bij het Belgische Mona Lisa Studio, dochteronderneming van Barry Callebaut, gaan dagelijks allerhande chocoladedecoraties de deur uit. Terwijl het bedrijf op maat
gemaakte producten levert, groeide intern juist de behoefte aan standaardisering. Een nieuwe versie van het ERP-systeem biedt soelaas.
De verfspatten van kunstenaar Jackson Pollock, metaalkleuren en de combinatie van verschillende iconen in de patisserie zijn een paar trends in de chocoladedecoratie. Bij Mona Lisa Studio, een dochteronderneming van de grootste chocoladefabrikant ter wereld Barry Callebaut, zitten ze er bovenop. Het bedrijf in het Belgische Kortrijk produceert

decoraties voor chocolade; van populaire klassiekers tot vernieuwende kunstwerken, en van ready-made decoraties tot make-ityourself tools. Items die patisserie, chocolade en desserts omtoveren tot echte eyecatchers.
De producten zijn bestemd voor de horeca, (banket)bakkerijbranche, en zuivel-, ijs-, en dessertindustrie. Sectoren waar de convenience-ontwikkeling natuurlijk niet aan voorbij gaat, vertelt customer care manager & supply chain manager Bieke Verstraete: “Vooral naar de afgewerkte items is de laatste jaren veel vraag. Vroeger leverden we veel transfer sheets waar klanten zelf mee aan de slag gingen; tegenwoordig maken we veel decoraties zelf.” De transfer sheets worden gebruikt om met behulp van sjablonen chocolade plaquetjes te maken. Een secuur klusje dat handmatig gebeurt en waarvoor in de productieruimte een hele afdeling is ingericht.
MET DE HAND
Waar Mona Lisa Studio zelf dus veel maatwerk levert, was aan de achterkant juist behoefte aan meer standaardisering. Orderbevestigingen, facturen, planningen maken; veel bedrijfsprocessen gebeurden tot een paar maanden terug vooral met de hand,
via excelsheets, mail én een zwaar verouderd ERP-systeem. Master data expert bij Mona Lisa Studio Lieke Rosseel: “Het werkte, maar efficiënt was anders. Vooral de planning was een uitdaging: ééns per dag haalden we de nieuwe orders uit Navision waarop de planning werd gebaseerd. Spoedorders die bijvoorbeeld een uur later vanuit een extern systeem binnenkwamen, bleven dan een dag liggen.”
PREHISTORIE
Ivar Slots, consultant bij softwarebedrijf Aptean, verklaart de manco’s van het systeem: “Het ging om een versie uit 1998, dat staat in ICT-land gelijk aan de prehistorie. Als een ERPsysteem zo oud is, wordt het ook niet meer ondersteund.”
Na een businesscase en goedkeuring vanuit het moederbedrijf werd vorig jaar gestart met de migratie naar een nieuwe versie van de software: Aptean Food & Beverage ERP op basis van Microsoft Dynamics 365 Business Central. De keuze voor Aptean lag voor de hand, vertelt Lieke: “Ons oude ERP-systeem kwam van de voorloper van Aptean en we waren heel erg te spreken over de begeleiding. Waarom overstappen als je tevreden bent?” En dus werd vanuit Aptean en Mona Lisa Studio een projectteam opgezet om de migratie
Bedrijfsreportage
©DIANE HENDRIKX
VOEDINGSINDUSTRIE APRIL 2024 20
Chef Stijn Vandenbouhede














































































































De Bieffel 3, 7622 BM Borne
T 074-2662905
E info@vanuhm.nl
W vanuhm.nl
VAN UHM ZORGT VOOR
Voedselverwerking van A tot Z
Bij Van Uhm professionals in food processing weten we precies wat er nodig is om een foodproces zo efficiënt mogelijk te laten verlopen. Machines mogen niet stil te komen staan en het oductieproces moet op rolletjes verlopen, elke dag weer.
Vlees, vis, kaas, groente, fruit, vegetarische en kant-en-klaar producten: onze professionals weten precies hoe uw foodproces verloopt en voorzien u van de juiste adviezen voor een optimaal productieproces.
Benieuwd naar de beste machines voor uw foodproces?
Vraag vrijblijvend een persoonlijk advies of een demo aan op www.vanuhm.nl/afspraak-maken












for Food
pro/foodnl
FAST-Solution
ERP | Productieplanning | Warehouse management | Mes Wegen en etiketteren | Tracering | Recepturenbeheer Blockchain & IoT | Kwaliteitsbeheer Expert in food-automatisering delaware
EEN ANDERE KIJK
Nieuwe ideeën ontspruiten vaak vanuit de diepste krochten van het menselijk brein. Eén manier om daar te komen, is door diep te graven. Door flink te spitten en te experimenteren, met keiharde kennis en wetenschap als tools, kom je tot innovaties. Maar er is ook een andere, zachtere, methode om dát deel van het brein te bereiken waar de creativiteit huist. De ingang? Het creatief denken van anderen: dat opent deuren waarvan je niet eens wist dat ze bestonden.
Ik ga graag naar musea en kunsttentoonstellingen. Kunst kan je zintuigen op scherp zetten. Het brein wordt uitgedaagd eens heel andere kronkels te maken, buiten zijn comfortzone te treden. Laatst was ik bij het Nxt Museum in Amsterdam, dat diepe indruk op mij maakte. Techniek en mijn aanwezigheid zorgden ervoor dat ik als kijker een wezenlijk onderdeel werd van het werk dat ik bekeek. Door mijn reactie veranderde de kunst. Niets was wat het leek, en wat voor mij gold was niet wat anderen zagen.
Zien en ervaren hoe ánderen de wereld zien, helpt mij om mijn eigen blik te verruimen. Vaak levert dit nieuwe perspectieven en inzichten op.
Maar al te vaak proberen organisaties te innoveren door samen met de hoofden van de R&D-, de productie- en/of de marketingafdeling in een saai kantoorhok te gaan brainstormen. Zou het niet fantastisch zijn om dat vanaf nu volslagen ánders te doen? De focus te verleggen? Niet zozeer te gaan graven, maar creativiteit de ruimte te geven?
De uitdaging: ga eens op zoek naar een andere omgeving. Naar nieuwe samenwerkingen. Kijk wat er gebeurt als je de creatieve potentie van je mensen werkelijk aanboort. Misschien gaat het resultaat je voorstellingsvermogen wel te boven.
Pieter Vos
Directeur Nutrilab

Column door Pieter Vos
VOEDINGSINDUSTRIE APRIL 2024 23


COASTAL SOUTHERN BBQ BURGER



Met de Master Sauce Coastal Southern BBQ wordt dit broodje hamburger echt een traktatie.











































Tolboomweg 16
3784 XC Terschuur
The Netherlands
+31 (0) 88 55 777 55
info@dkbfoodsolutions.com
www.dkbfoodsolutions.com













Sluit je ook aan bij OSV Netwerk!
www.osvnetwerk.com
PRAKTISCHE HANDLEIDING:
LISTERIAPROTOCOL
Veel bedrijven in de voedingsindustrie hebben hun Listeria-probleem kunnen oplossen met hulp van SimpelDesinfecteren. Dit bedrijf levert al jarenlang met succes het Nocotech desinfectiesysteem aan de voedingsindustrie. Het systeem is zeer effectief in het verlagen van de infectiedruk.
Nocomax wandmodel
Steeds vaker vragen de bedrijven niet alleen om het Nocotech desinfectiesysteem, maar doen ze ook een beroep op de expertise van de mannen achter SimpelDesinfecteren: Hugo ter Hoeve en Robert Kostrubiec. “Om een probleem als een Listeriabesmetting goed aan te pakken, is een complete benadering nodig,” legt Hugo ter Hoeve uit. “Dit houdt in dat je naar heel veel zaken moet kijken. Je moet het hele reinigingsproces onder de loep nemen, bekijken of -en zo ja hoe - er sprake is van het verslepen van bacteriën van ruimte naar ruimte, hoe de luchtverversing en de verdampers werken;
maar ook naar zaken als monstername, persoonlijke hygiëne, preventieve maatregelen, etcetera. Het is allemaal relevant voor het totaalplaatje en het vinden van de juiste oplossing.”
PRAKTISCH HULPMIDDEL
Om bedrijven extra te ondersteunen, heeft SimpelDesinfecteren nu een ‘Listeriaprotocol’ ontwikkeld, daarbij gebruikmakend van hun brede ervaring met voedselveiligheidssystemen als HACCP, BRC, FSSC 22000 en IFS. “Ons protocol vormt een praktische handleiding voor

bedrijven. Het is een standaard waaraan ze hun processen kunnen toetsen, en een hulpmiddel om deze te verbeteren.”

Hugo en Robert zien goede resultaten bij de bedrijven die dit al toepassen. “Uiteraard speelt Nocotech desinfectie hierin een belangrijke rol”, benadrukt Robert. “Afhankelijk van de mate van besmetting wordt de dosering gedurende een bepaalde periode bepaald. Is er een neerwaartse trend in de besmettingen te zien, dan kan de dosering worden aangepast. Dit gebeurt dus trapsgewijs. Er blijft een bepaalde dosering nodig; die zorgt ervoor dat Nocotech de infectiedruk laag houdt, zodat microorganismen geen kans krijgen uit te groeien.”
VOLLEDIG GEAUTOMATISEERD
“De rol van Nocotech is naast alle andere maatregelen dus best groot”, vat Hugo samen. “Gebruikers zien aan de uitslagen van het laboratorium dat het beter werkt dan handmatige desinfectie. Groot voordeel is dat het systeem volledig geautomatiseerd is; er kunnen dus geen menselijke fouten meer worden gemaakt. Dankzij het gebruik van de module en het dashboard is alles onder controle, en vanaf telefoon of PC te regelen. Elke behandeling is traceerbaar. Simpeler kunnen we het niet maken.”
Voedselveiligheid
www.simpeldesinfecteren.nl
VOEDINGSINDUSTRIE APRIL 2024 25
door Esther van der Lelie | foto’s ©Studio38C
RENOVEREN IS INNOVEREN
MET EEN VERNIEUWDE WERKOMGEVING TROTS DE TOEKOMST IN
Het professionaliseren van de werkomgeving was de wens. Een vernieuwde antibacteriële en hygiënische productielocatie is het resultaat. Door een slimme renovatie-aanpak worden dromen werkelijkheid voor vleesverwerkersbedrijf Henri van de Bilt in Beuningen. De samenwerking met Jack-it Sealwise zorgt ervoor dat ze hun ambities voor de toekomst kunnen waarmaken.

“Vanwege de steeds strengere eisen op het gebied van voedselveiligheid wilden we een professionaliseringsslag in onze fabriek maken”, vertelt Jeroen van Ginkel. Hij is sinds januari 2022 maintenance manager van varkensvleesverwerker Henri van de Bilt in Beuningen. Een familiebedrijf dat onderdeel is van de OSI-groep, wereldwijd marktleider in voedselproductie. “Ik houd van mijn werk in de vleesindustrie, ik ben trots op ons bedrijf en ons product. Kwaliteit staat altijd voorop, daar leveren wij ‘nul procent’ op in”, benadrukt Jeroen.
GEVOLGEN VAN ZOUT, VET EN REINIGINGSMIDDELEN
In 2019 werd een 6.000 m2 grote productiehal aan de bestaande fabriek in Beuningen gebouwd die hiermee 20 hectare groot werd. Jeroen: “In onze fabriek verwerken we diverse vleesproducten, tot en met ready-to-eat. Door het dynamische productieproces moet er
regelmatig gereinigd worden. Hierdoor ontstaan kleine beschadigingen op wanden. Deze herstellen we direct, aangezien die kunnen uitgroeien tot bacteriehaarden, wat ten koste gaat van de voedselveiligheid.” Esthetisch gezien werd de fabriek er niet mooier op.
OPLOSSING MET ANTIBACTERIËLE WANDPANELEN
Op LinkedIn las Jeroen berichten van Jack Pluim van Jack-it Sealwise. Met de situatie in de fabriek in zijn hoofd, nam hij contact op. Jack kwam langs, de problematiek werd besproken en de samenwerking beklonken. Onderzocht werd of opnieuw spuiten en kitten van de wanden het gewenste resultaat zou opleveren. Dit leek er niet op. “Vervangen was onbegonnen werk omdat dit te veel downtime zou opleveren.
Voor het bedrijf is het een must dat de basiswanden, vloeren en plafonds - op orde is.”
“De beste optie was het aanbrengen van een tweede laag met Sealwise”, vult Jack aan. Dit

Bedrijfsreportage
VOEDINGSINDUSTRIE APRIL 2024 26

zijn onze sterke, waterdichte, antibacteriële, antivirale, zelfs bacteriedodende panelen van gerecycled pvc die ook voldoen aan brandklasse A1.” Jeroen en Jack waren zich ervan bewust dat deze renovatie een enorme uitdaging was, want dit moest in de gehele fabriek gebeuren.
VERBETEREN KWALITEIT WERKOMGEVING
In maart 2022 startten Jack en zijn collega’s met de klus. Ruimte voor ruimte werd, én wordt, aangepakt. Op uniforme wijze. De jongens van Jack-it brengen de Sealwise panelen aan, met randbeveiliging om beschadigingen door onder meer de grote elektrische pompwagens te voorkomen. Vervolgens kitten ze deze af met Inotec dat bewezen bestand is tegen vuil én reinigingsmiddelen. Het is een continu proces om de kwaliteit van de werkomgeving naar een hoger niveau te tillen. Jack: “Zonder dat de
productie stil staat, want we werken buiten de productietijden, ook in de weekenden.”
TRANSPARANTE SAMENWERKING
Jeroen is enorm tevreden met de samenwerking met Jack. “Hij kijkt naar de activiteiten en kiest de juiste componenten waarmee hij het bedrijf zo lang mogelijk vooruit kan helpen. Je weet precies waar je aan toe bent. Hij is recht door zee, transparant en berekent alleen het werk wat ook daadwerkelijk wordt uitgevoerd.” Jack luistert aandachtig. Hij beaamt de uitspraken van Jeroen kort en krachtig met “Dat klopt”. Hij laat weten trots te zijn op het werk van ‘zijn jongens’. “We werken hier met een vaste ploeg waarop ik kan vertrouwen. We krijgen de vrijheid om ons werk te doen, dat is fijn. Ik volg de inzet van de jongens kritisch, want de kwaliteit van ons werk moet goed zijn. Er is geen tussenweg, anders
ontstaan er later toch problemen. We maken geen lappendeken, het is één mooi geheel.”
TOEKOMSTGERICHTE INNOVATIE
Vóór de zomer zal dit renovatieproject klaar zijn. Dan zien Jeroen en zijn 120 collega’s de in 2022 geuite wens voor professionalisering werkelijkheid worden. Een belofte voor de toekomst, want met de kwalitatief nog hoogwaardigere basisomgeving kan Henri van de Bilt werken aan haar ambitie: consistentie van het product en het steeds mooier en beter maken van de smaak. Zo draagt de renovatie bij aan innovatie richting de toekomst.
www.osieurope.com/en/brand/ henri-van-de-bilt www.jackit.nl
VOEDINGSINDUSTRIE APRIL 2024 27
Jeroen van Ginkel (links) en Jack Pluim
CIJFERS & FEITEN
EIWITBOEREN ONDER DRUK DOOR PRIJSDALINGEN

De producentenorganisatie Eiwitboeren van Nederland, een collectief van telers van peulvruchten, ervaart een significante daling in de prijzen van hun gewassen in 2024. Kidneybonen kennen een verlaging van 24% ten opzichte van het voorgaande jaar. Bruine bonen en kapucijners volgen met respectievelijk 17% en 13%. Deze prijsveranderingen zijn niet zonder gevolgen. Afnemers rechtvaardigen deze daling door te wijzen op de dalende wereldwijde
graanprijzen. De Eiwitboeren van Nederland stellen echter vraagtekens bij deze redenering, gezien de aanzienlijke verschillen tussen graan en peulvruchten in teelt, voedingswaarde en marktsegmentatie. Dit brengt een nieuwe discussie op tafel over de prijsvorming en waardering van deze gewassen in de huidige voedselketen. www.eiwitboeren.nl


DUURZAAMHEID, WETGEVING
EU ZET IN OP ONTBOSSINGSVRIJE PRODUCTEN VANAF 2025
De Europese Unie zet een grote stap vooruit in de strijd tegen wereldwijde ontbossing. Vanaf 30 december 2024 zal de nieuwe Verordening voor Ontbossingsvrije Producten van kracht zijn. Deze verordening legt strikte eisen op aan het op de Europese markt brengen van bepaalde producten. Het hoofddoel is het verminderen van ontbossing en bosdegradatie, die vaak het gevolg zijn van EU-consumptie en productie. De verordening richt zich op het verhogen van de vraag naar goederen en producten die legaal en zonder ontbossing geproduceerd zijn. Belangrijk hierbij is het effect van mondiale ontbossing, die leidt tot verlies van biodiversiteit en bijdraagt aan 10 tot 20% van de wereldwijde uitstoot van broeikasgassen. De EU streeft ernaar haar CO2-uitstoot te verminderen door de productie van deze goederen te reguleren.
www.rijksoverheid.nl
DATA
DUURZAAMHEIDSDATA DELEN: GS1 ZET DE TOON
De Nederlandse voedingsindustrie staat voor een cruciale uitdaging: duurzaamheid integreren in elke stap van de productieketen. Een recente ontwikkeling is de nadruk op het delen van duurzaamheidsdata, waarbij GS1 Nederland een sleutelrol speelt. Deze aanpak belooft transparantie en circulaire innovatie in de sector te stimuleren. Het hart van deze ontwikkeling is de QR-code van GS1, dat als instrument dient om een breed scala aan duurzaamheidsgegevens beschikbaar
te maken. Volgens Mirjam Karmiggelt, CEO van GS1 Nederland, is de uitdaging om data door de hele keten te laten stromen. Dit vereist niet alleen het vastleggen van informatie op productniveau, maar ook de ontwikkeling van nieuwe standaarden en tools. Deze ontwikkelingen zijn essentieel om duurzame beslissingen te kunnen nemen en consumenten adequaat te informeren.
www.gs1.nl
Nieuws
VOEDINGSINDUSTRIE APRIL 2024 28

VISSERIJ
TIENTALLEN MILJOENEN VOOR TOEKOMST VISSERIJKETEN
Minister Piet Adema van Landbouw, Natuur en Voedselkwaliteit (LNV) heeft onlangs een belangrijke stap gezet ter ondersteuning van de Nederlandse visserijsector. Hij heeft het Visserij Ontwikkel Plan (VOP) goedgekeurd, een samenwerkingsinitiatief van vijf visserijregio’s. Dit plan biedt niet alleen toekomstperspectief voor ketenbedrijven aan wal, maar ook voor de visserijgemeenschappen. Het VOP omvat een reeks van innovatieve projectvoorstellen, variërend van een ‘shrimp innovation center’ tot het omzetten van visresten in hoogwaardige voeding. Het doel is om tot 2030 € 80 miljoen te investeren in deze projecten, waarbij minister Adema € 30 miljoen heeft toegezegd en de regio’s de rest financieren. www.rijksoverheid.nl

BEDRIJFSSTRUCTUUR

MONITOR NVB
MINDER VERSPILLING VAN BROOD EN BANKET
De Nederlandse bakkerijsector toont aanzienlijke vooruitgang in het terugdringen van voedselverspilling. Onlangs heeft de Nederlandse Vereniging voor de Bakkerij (NVB) bekendgemaakt dat de inspanningen om reststromen en verspilling te verminderen vruchten afwerpen. De NVB zet zich in om de reststromen in de keten transparant te maken, wat al heeft geleid tot een duidelijke reductie ervan: het aantal retouren van brood is met maar liefst 30% gedaald sinds 2020. De NVB benadrukt het belang van monitoring als een essentiële factor in dit succes. De bakkerijsector vindt ook creatieve oplossingen voor reststromen die toch ontstaan. Zo wordt overtollig brood vaak omgezet in diervoeder, een methode die als duurzamer wordt beschouwd dan bijvoorbeeld vergisting of compostering.
www.nedverbak.nl
UNILEVER NEEMT AFSCHEID VAN IJSDIVISIE
Unilever kondigde een ingrijpende verandering aan in haar bedrijfsstructuur. Deze wijziging omvat het afsplitsen van de ijsdivisie en het introduceren van een omvangrijk productiviteitsprogramma. Deze stappen zijn onderdeel van het ‘Growth Action Plan’ (GAP), gericht op het verscherpen van de bedrijfsfocus en het stimuleren van duurzame groei. De ijsdivisie, die in 2023 een omzet van €7,9 miljard realiseerde, omvat topmerken zoals Wall’s, Magnum en Ben & Jerry’s. Deze stap maakt het mogelijk dat de ijsdivisie zich als zelfstandige onderneming verder kan ontwikkelen en investeren in zijn unieke strategie en operatie. De verwachting is dat de volledige afsplitsing eind 2025 zal zijn voltooid.
www.unilever.nl

VOEDINGSINDUSTRIE APRIL 2024 29

EIGEN VERANTWOORDELIJKHEID NEMEN
Na jarenlang werk van de Europese Commissie is de Corporate Sustainability Due Diligence Directive (CSDDD) bijna een feit. Recent bereikten de EU-lidstaten - na aanvankelijk nieuw verzet - alsnog een akkoord. De richtlijn verplicht bedrijven tot meer aandacht voor mensenrechten en milieu in hun productie- en toeleverketens.
De Corporate Sustainability Reporting Directive (CSRD) verplicht grote bedrijven al om over arbeidsomstandigheden en milieukwesties in hun toeleverketens te rapporteren. Deze Europese duurzaamheidsrapportagerichtlijn geldt voor beursgenoteerde bedrijven vanaf het verslagjaar 2024. Grotere bedrijven die voldoen aan de CSRD-criteria moeten al rapporteren vanaf 2025.
Het is de hoogste tijd om werk te maken van eerlijke productieketens en op te komen voor arbeidskrachten in lokale gemeenschappen. Een Europese aanpak heeft de voorkeur om misstanden op een gelijke manier aan te pakken. Momenteel valt echter slechts 1/3e van de oorspronkelijke bedrijven onder het akkoord, namelijk bedrijven met >1000 werknemers (was 500) en met >450 miljoen euro omzet (was 150 miljoen). Het zet veel meer zoden aan de dijk als voedingsbedrijven zélf actie ondernemen en hun verantwoordelijkheid nemen voor eerlijke productieketens. Zeker nu deze ‘antiwegkijk-wet’ voor de zoveelste keer nog verder is afgezwakt.
Consumenten eisen transparantie over de productie van hun voeding en onder welke omstandigheden die plaatsvindt. Nu welbevinden en inclusie meer aandacht krijgen, is het des te belangrijker serieus werk te maken van maatschappelijk verantwoord ondernemen.
Voedingsbedrijven kunnen niet langer wegkijken: van uitbuiting van tomatenplukkers in Zuid-Italië, mistanden op theeplantages in Kenia, of dichter bij huis: ernstige werk- of huisvestingssituaties van arbeidsmigranten. Voor voedingsbedrijven en supermarkten is het tijd hun sociale hart (meer) te tonen door mensenrechtenmisstanden in hun productieketens écht serieus aan te pakken. Dat geldt ook voor bedrijven die niet onder de CSDDD vallen.
Ceel Elemans
ING Sector Banker Food

Column door Ceel Elemans
©JASPER LENSSELINK VOEDINGSINDUSTRIE APRIL 2024 31
RECYCLING
PRODUCTIE RECYCLAAT STOKT

De Nederlandse plastic sorteeren recyclingindustrie staat onder hoogspanning. De branche, vertegenwoordigd door de Vereniging Afvalbedrijven, waarschuwt voor een dreigende crisis. Deze situatie brengt niet alleen de klimaatdoelen in gevaar, maar heeft ook directe gevolgen voor de productie van gerecycled plastic, oftewel recyclaat. De concurrentie van goedkoop, nieuw geproduceerd plastic uit Azië
SUBSIDIE

INNOVATIE
MARIENE BIOMASSA:
DUURZAME BRON VOOR VOEDING
en Amerika vormt een aanzienlijke uitdaging. De stagnatie in omzet en de ophoping van voorraden dwingen recyclingbedrijven om hun productie te verlagen. Als reactie hierop heeft de branche een brandbrief gestuurd naar demissionair staatssecretaris Heijnen van Infrastructuur en Waterstaat, met daarin voorstellen ter ondersteuning van de markt.
www.verenigingafvalbedrijven.nl
DIGITALE TRANSFORMATIE IN AGF-KETENS
Een consortium onder leiding van de Rotterdam School of Management en Docklab heeft onlangs een subsidie van bijna een half miljoen euro ontvangen. Deze subsidie zal worden aangewend voor een project dat focust op de digitalisering van de AGF-ketens tussen Kenia, Nederland en het Verenigd Koninkrijk. De nadruk ligt op het verbeteren van de productkwaliteit en het naleven van ESG-normen (Environmental, Social, and Governance) binnen deze ketens. Door de recente verschuiving naar digitalisering biedt dit project een unieke kans om dit proces te versnellen.
www.groentenfruithuis.nl
Innovatief gebruik van mariene biomassa speelt een cruciale rol in de ontwikkeling van duurzame producten. Laag trofische mariene soorten zoals mosselen vormen hierin een belangrijk element. Ze vereisen geen landbouwgrond of zoetwaterbronnen. Dit maakt ze een ideale kandidaat voor circulaire en klimaatneutrale toepassingen. Mosselkweek, met name in hangculturen, biedt meerdere voordelen. Het draagt bij aan de biodiversiteit en vereist beperkte ruimte. Belangrijker nog, deze vorm van aquacultuur heeft minimale impact op de zeebodem. Hierdoor past mosselkweek uitstekend binnen een circulair voedselsysteem. Dit systeem sluit aan bij de groeiende behoefte aan duurzame voedselproductie.
www.wur.nl

Nieuws
VOEDINGSINDUSTRIE APRIL 2024 32
JUMBO STOPT MET VLEESPROMOTIES
De Nederlandse supermarktketen Jumbo heeft aangekondigd te stoppen met vleespromoties in al haar filialen en online. Dit initiatief markeert een belangrijke verschuiving in het supermarktlandschap. Het is onderdeel van Jumbo’s strategie om in 2030 zestig procent van de verkochte eiwitten uit plantaardige bronnen te halen. Deze ambitie weerspiegelt een groeiend bewustzijn van duurzaamheid en gezondheid onder consumenten en bedrijven. Jumbo streeft naar een evenwichtige verdeling van 50% plantaardige en 50% dierlijke eiwitproducten in 2025. Dit tussentijdse doel maakt deel uit van de grotere ambitie voor 2030.
www.jumbo.com

ROBOTISERING
AGROBOTS: DE TOEKOMST VAN DUURZAME LANDBOUW
De Nederlandse land- en tuinbouwsector staat voor een belangrijke transitie met als doel natuur en landbouw in balans te brengen. Een sleutelrol in deze ontwikkeling is weggelegd voor geavanceerde landbouwrobots, bekend als agrobots. Deze technologische vernieuwing wordt mogelijk gemaakt door een uniek samenwerkingsverband tussen bedrijven en Noord-Nederlandse kennisinstellingen. Agrobots kunnen taken uitvoeren variërend van gewascontrole tot onkruidbestrijding. Het project, geleid door TNO, streeft naar de ontwikkeling van deze robots om de landbouw efficiënter en duurzamer te maken.


VOEDSELVERSPILLING DE WINST VAN KLEINERE PORTIES
Amber Werkman, promovenda in de marketing bij Rijksuniversiteit Groningen, presenteert een vernieuwende aanpak in de strijd tegen overconsumptie en voedselverspilling: het stimuleren van kleinere porties. Haar focus lag op de impact van portiegrootte op snoepgedrag en verspilling. Haar onderzoek toonde aan dat consumenten minder snoepen én verspillen wanneer ze hun totale portie kunnen bepalen met behulp van kleinere eenheden. De reden hierachter is tweeledig: kleinere eenheden geven het gevoel meer te eten, waardoor men eerder stopt, en het stelt consumenten in staat hun behoefte nauwkeuriger te bepalen, wat leidt tot minder verspilling.
www.rug.nl
VOEDSELVEILIGHEID
7 OP DE 10 NEDERLANDERS EIST HALVERING PESTICIDENGEBRUIK
De Nederlandse landbouwsector staat in de schijnwerpers, nu niet vanwege zijn successen, maar vanwege het intensieve gebruik van pesticiden. Recent onderzoek in opdracht van PAN Netherlands wijst uit dat 70% van de Nederlanders voorstander is van een halvering van het pesticidengebruik. Daarnaast pleit 73% voor een verbod op de 30 meest giftige pesticiden tegen 2030. De wens onder de Nederlandse bevolking voor strengere regelgeving en een verschuiving naar biologische landbouw is dus groot. Hoewel andere EU-lidstaten de overgang naar biologische landbouw financieel steunen, blijft Nederland terughoudend. PAN-NL roept politieke partijen op om gehoor te geven aan deze publieke oproep door chemische bestrijdingsmiddelen te vervangen door mechanische methoden en te investeren in duurzame alternatieven.
www.pan-netherlands.org

RETAIL
VOEDINGSINDUSTRIE APRIL 2024 33
FOOD TECH EVENT 2024
Het Food Tech Event is dé vakbeurs voor managers en professionals in de voedselindustrie: hier ontdek je de nieuwste innovaties en technologische ontwikkelingen. De slogan voor de beurs: Techniek voedt de toekomst van de voedingsindustrie.
Het Food Tech Event verbindt de gehele keten om samen te werken aan oplossingen voor (toekomstige) uitdagingen: denk aan een duurzamere en transparante supplychain, stijgende productiekosten, het groeiend arbeidstekort, grondstofschaarste en veranderende consumentenbehoeftes. Efficiëntere en duurzamere processen met minimale verspilling, kwaliteitsborging, voedselveiligheid en hygiëne zijn hierbij essentieel. Oplossingen zijn onder meer te vinden in vernieuwingen als robotisering,
sensortechniek, cloud computing, internet of things en sturen op data.
COMPLEET OVERZICHT
“Dat kan allemaal best uitdagend zijn, zeker in het mkb. Het is dus noodzaak om hier goed op in te spelen en kennisdeling over deze onderwerpen te stimuleren”, vertelt Judith van den Nieuwenhuijzen, programmamanager Food Tech Event. “Met Food Tech Event creëren we een jaarlijkse ontmoetingsplek voor directie, management en technische professionals


15 en 16 mei 2024
Brabanthallen ‘s-Hertogenbosch
van voedselverwerkende bedrijven en de drankenindustrie.”
DE BEURSVLOER
Op de beursvloer ontmoet je zo’n 100 specialistische bedrijven met op food en beverage gerichte oplossingen voor jouw productie- of verwerkingsomgeving. De focus ligt daarbij op zes actuele thema’s:
• Techniek, machine- en apparatenbouw
• Voedselveiligheid en hygiëne
• Future Food Factory
• Kwaliteitsmanagement en -beheersing
• Energiemanagement en-besparing
• Leven Lang Ontwikkelen
EEN GREEP UIT DE HIGHLIGHTS
Het programma omvat interactieve workshops, inspirerende lezingen en keynotes door vooraanstaande experts, waaronder Bolletje & Qing en GEA Food Solutions. Op de Demo Area kunnen bedrijven live hun technieken aan het publiek demonstreren en op de Young Talent Area maak je kennis met start-ups en studententeams. Ook komt er een interactieve demonstratie met artificial intelligence door Staubli en Qing. Bezoek de paneldiscussies door GMV & EVMI en Next Tech Food Factories, en spijker je kennis bij tijdens de seminars georganiseerd door Vakblad Voedingsindustrie, EHEDG en Water Alliance. Natuurlijk is er ook een gezellige netwerkborrel.
www.food-tech-event.nl
Kom luisteren naar inspirerende lezingen en keynotes door vooraanstaande experts. Het volledige programmaoverzicht vind je op de site. Hieronder zoomen we in op het programma op 16 mei dat georganiseerd wordt door Vakblad Voedingsindustrie.

VERGROENING VAN HET ENERGIEGEBRUIK VERGT MEER ACTIE
Voedingsbedrijven worden geacht bij te dragen aan de Nederlandse klimaatdoelstellingen. Met alleen groene stroom van eigen zonnepanelen en uit windparken wordt de branche niet klimaatneutraal. De opgaves: elektrificatie van productieprocessen en sturen op energieefficiency. Wat zijn de drijfveren van bedrijven om te vergroenen? Welke obstakels liggen er op de weg? Scope 1 en 2 vormen al een uitdaging, maar hoe zit het met scope 3? Toenemende wetgeving dwingt bedrijven tot CO2-reductie, maar is dat de beste motivator?
Als sectorspecialist volgt Ceel Elemans de ontwikkelingen in o.a. de voedingsindustrie en -groothandels en foodservice voor ING in Nederland. Doelen: delen en objectief duiden van sectorkennis met ondernemers en brancheorganisaties en sectortrends en innovaties vertalen in werkbare toepassingen.
50% TIJDWINST: INTEGREER AI DIRECT IN JOUW BEDRIJF

Til jouw sales naar een hoger niveau met AI: de katalysator in klantconnectie en marktinzicht. In deze lezing vertellen we jou hoe AI je salesstrategie verbetert, resultaten verdubbelt en je marketingcommunicatie versterkt. Verwacht geen alledaags verhaal; bereid je voor op een gamechanger in de voedselindustrie. Zorg dat je erbij bent en laat deze innovatie niet aan je voorbijgaan.
John Wallbrink brengt je meer dan 12 jaar ervaring in AI als strategische AI prompt consultant. Hij helpt je bij het verfijnen van je vragen om de beste resultaten te behalen met AI, ChatGPT en Google Gemini.
DE SMART FOOD FACTORY VAN MORGEN

‘Lights-out fabrieken’ lijken de heilige graal van toekomstige productie: realiteit of slechts een visie voor de toekomst? Ontdek de blauwdruk van de slimme voedselfabriek van morgen en leer over concrete strategieën waarmee je vandaag al je operatie kan verbeteren. Hoe optimaliseer je het gebruik van hulpbronnen en pak je de uitdagingen op het gebied van arbeid en toeleveringsketens aan? John geeft een inzichtelijke verkenning van state-of-theart automatisering, slimme ERP-oplossingen, efficiënt beheer van de toeleveringsketen, robotica en AI-gedreven visiontechnologie.
Jorn Ballas is 9 jaar werkzaam bij CSB als verkoopconsultant. Zijn betrokkenheid bij talrijke projecten toont niet alleen zijn analytische expertise, maar ook zijn vermogen om effectieve CSB-System oplossingen op maat te maken voor implementatie.
Ceel Elemans, Sector Banker Food ING
John Wallbrink, CEO - Crossmedia Academy
VOEDINGSINDUSTRIE APRIL 2024 35
Jorn Ballas, Sales ManagerCSB-System Benelux B.V.
Food Tech Event in beeld
DE TOEGEVOEGDE WAARDE VAN DIGITALISERING
‘TECHNIEK VOEDT DE TOEKOMST VAN DE VOEDINGSINDUSTRIE’
De digitale ontwikkelingen gaan snel en brengen efficiency. Maar welke technologische innovaties hebben voedingsbedrijven nodig om met een gerust hart de toekomst in te gaan? Hoe weten zij welke oplossing het beste bij hun
bedrijf past en ook de productkwaliteit kan borgen? Vier toeleveranciers voor de voedselverwerkende en -producerende industrie geven antwoord.
Ketenintegratie, verduurzaming, kostenreductie, productieautomatisering en -verhoging en gecontroleerde kwaliteit zijn zes belangrijke aandachtspunten voor voedingsbedrijven. Zij moeten op dit gebied innoveren gezien de huidige personeelskrapte, de sterk stijgende kosten en nieuwe weten regelgeving. Op het Food Tech Event op 15 en 16 mei 2024 in de Brabanthallen in ’s-Hertogenbosch kunnen zij zich bij meerdere experts oriënteren op technologische oplossingen.
Vijf experts geven alvast een voorproefje en gaan in op de behoeften die zij waarnemen in de foodsector. Hans de Wit, mede-eigenaar DNA Services B.V., Bram de Vrught, medeeigenaar QING, Will Uijting, commercieel directeur QING, Jan Buit, Segment Manager Pharma & Food NL Staubli en Joris Kolff, Sr. Director, Strategic Project(s) F&B Aptean, zijn allen gespecialiseerd in het ontwikkelen
en implementeren van integrale, innovatieve, technologische oplossingen. Ze kennen de knelpunten, uitdagingen én oplossingen.
Waar is volgens jullie op dit moment vooral behoefte aan als het gaat om de digitaliseringsslag in de voedselverwerkende industrie?
Joris Kolff trapt af: “De behoefte is breed en wordt veroorzaakt door een aantal trends: stijgende kosten, hoge inflatie, onzekerheid op het gebied van grondstoffen, veranderende consumentengedrag en duurzaamheid. Bedrijven moeten veel wendbaarder zijn dan voorheen. Dat betekent dat ze af willen van de verschillende custom made, vaak losse, software-oplossingen. Ze hebben behoefte aan één digitaal platform als goede fundering, dat meebeweegt en altijd up-to-date is.”
Hans de Wit herkent dit fenomeen: “We zien bij foodbedrijven inderdaad nog te vaak data uit meerdere systemen zonder dat er
interactie is tussen de verschillende systemen. Ketenintegratie is het sleutelwoord.”
Will Uijting benadrukt dat digitalisering geen doel op zich is. “Een productie-automatisering moet bepaalde behoeftes oplossen en een gewenst kwaliteitsniveau garanderen. Bedrijven hikken echter vaak lang aan tegen besluiten om te innoveren.”
“Die tijd is er niet meer”, voegt Jan Buit toe. “Willen zij hun concurrentiepositie behouden, dan is het zorg om nu stappen te zetten. Vanwege de vergrijzing, lage instroom en hoge kosten moet de productie per werknemer omhoog. Dat betekent digitaliseren. Robotisering en AI gaan een belangrijke rol spelen. ”
Wat zijn de knelpunten en uitdagingen? Uit de reactie van de experts blijkt dat veel foodbedrijven werken met verouderde systemen en meerdere softwareoplossingen

VOEDINGSINDUSTRIE APRIL 2024 36
door Esther van der Lelie

VOEDINGSINDUSTRIE APRIL 2024 37
Food Tech Event in beeld

zonder integratie. En dat een aantal bedrijven nog bestellingen handmatig verwerkt met het risico op foutieve verwerking van data. Ze horen dat bedrijven wel willen moderniseren en zich bewust zijn van de noodzaak, maar vaak niet weten hoe. Want wat is de eerste stap naar vernieuwing? Welke technologische oplossingen zijn er? Hoe kan je bijvoorbeeld een productieproces met organische vormen met afwijkende dimensies, zoals paprika’s of vleesdelen, automatiseren? Welk systeem sluit het beste bij het bedrijf aan? Hoe wordt voortgang geborgd; de productie moet altijd doorgaan! Wat betekent dit allemaal voor de huidige medewerkers? Wat zijn de kosten?
Hoe spelen de experts met hun technologische innovaties op deze vragen in? Will Uijting: “We gaan in gesprek en schetsen twee startbenaderingen: vanuit onderzoek; wat is bedrijfsspecifiek en welke oplossing vraagt dat? En vanuit ervaring; we zien wat nodig is en kunnen met onze ‘standaard’applicaties snel een digitaliseringsslag maken. Daarbij denken we niet vanuit de
bestaande situatie op basis van machines, we kijken vooral naar wat er technologisch mogelijk is. Je kunt bijvoorbeeld AI of Vision toepassen voor beeldherkenning in het productieproces.”
“Dat kan inderdaad bij de eerdergenoemde paprika’s”, vult Jan Buit aan. “Als mens zie je de verschillende formaten. Een robot op de productielijn ziet dat niet. Met de integratie van AI of Vision lukt dat wel, dan breng je herkenning in. Zo’n proces is complex. Wij maken deze specifieke robots voor de food. Waarbij we ook letten op de omgevings- en hoge hygiëne-eisen. De robot moet bestendig zijn tegen het reinigen met water en chemische schoonmaakmiddelen.”
Hans de Wit noemt nog een ander voorbeeld: “Bij een retailer moest de herkomst van vlees zichtbaar voor de consument worden. Dit is door ons opgelost door in samenwerking met de leverancier een qr-code op de verpakking te plaatsen. Als de consument die code scant, is meteen te zien waar het vlees verwerkt is. Dit gaat niet alleen over het ‘aan elkaar knopen’
van systemen, maar tevens over transparantie en data-uitwisseling. Het is een totaalplaatje dat moet kloppen. ”
Ook Joris Kolff hecht waarde aan het realiseren van oplossingen die kloppen en ervoor zorgen dat de coreprocessen van het voedingsbedrijf doorlopen. “Een goede fundering behelst data van de financiële afdeling, de operatie, logistiek en distributie. Daarbij kunnen we extra lagen aanbrengen, bijvoorbeeld voor een OEE rapportage of de introductie van een MESsysteem. Met alle data kun je werknemers inzicht geven en laten sturen op realtime data. Daarnaast kan de behoefte ontstaan om de maintenance verder te optimaliseren met EAM, om bijvoorbeeld storingen in machines te voorkomen en onderhoud te voorspellen op basis van historie.”
Hoe draagt dat bij aan verbetering van het proces; bijvoorbeeld in efficiëntie, kwaliteit of duurzaamheid?
“Automatisering is nodig om de bedrijfsprocessen te borgen. Gezien de

VOEDINGSINDUSTRIE APRIL 2024 38
©STÄUBLI
personeelskrapte, stopt het handwerk,” zegt Hans de Wit en stipt vervolgens de voordelen efficiency en werkplezier aan: “De taken van bijvoorbeeld verwerken inkoopfacturen - controleren, goedkeuren, inboeken – zijn omslachtig. Met onze oplossing, waar scanen herkenningsoftware is ingebouwd, niet meer. Het systeem scant een factuur die in de e-mail-inbox verschijnt, herkent of het een inkoopfactuur is, checkt of het bedrag klopt en kan de factuur zo goedkeuren. Alleen het betaalbaar stellen voor de bank gebeurt niet geheel automatisch, dat wil je niet volledig automatiseren.”
Jan Buit noemt een andere praktijkcase met voordelen door automatisering: “We kunnen ervoor zorgen dat in het proces van orders pikken er bij bepaalde stappen foto’s worden gemaakt. Bijvoorbeeld hoe een product de vrachtwagen in gaat en hoe vervolgens de bezorging heeft plaatsgevonden. De foto’s gelden als bewijs van transactie in de keten en worden automatisch achter de opdracht gearchiveerd.”
Bram de Vrught bekommert zich ook om de mens: “We mogen het menselijke aspect niet vergeten. We moeten hen meenemen in de
modernisering, voldoende draagvlak creëren om de automatisering goed te laten landen. Het gaat niet alleen om het oplossen van problemen, maar ook om het hebben van de juiste mensen in het bedrijf, en om hen met training en support te helpen bij de integratie. Dan weet je zeker dat de oplossing waarde blijft toevoegen.”
“Je kunt inderdaad niet van 0 naar 100 in vijf seconden”, bevestigt Joris Kolff. “Een moderniseringsslag maken met het bedrijf én de mensen die er werken, vraagt tijd, aandacht en een meerjarenplan. Vanwege personeelskrapte en hoog verloop kun je er niet altijd meer op vertrouwen dat medewerkers de processen kennen. Dan geeft automatisering uitkomst. Het vraagt ook vooruitkijken, zodat je nu al op de juiste manier een ERP-systeem kunt inrichten voor de uitdagingen die gaan komen. Technologie blijft zich ontwikkelen. De verwachting is dat we binnen twee jaar aan het ERP-systeem vragen kunnen stellen over cashflow of voorraad.”
Welke innovaties kan de bezoeker op jullie stands zien?
Aptean zet in op de integrale aanpak.

Joris Kolff: “Met voorbeelden willen we de bezoekers gevoel geven, laten zien dat integrale aanpak efficiënter is dan één stukje software vervangen en later weer een deel. Ze kunnen kennismaken met onze expertise en diensten (ERP, OEE, EAM, MES, PLM) die we inzetten om klaar te zijn voor de toekomst.”
DNA Services toont op hun stand onder meer de ‘Scan en Herken’ oplossing voor inkomende factuurstromen. En daarnaast toepassingen zoals Foto-Apps en Track & Trace Apps als voorbeeld van klantspecifieke applicaties.
Hans de Wit: “We zijn een specialist in het leveren van ERP-software, het ontwikkelen van klantspecifieke software en het bouwen van API-koppelingen. We kijken met bedrijven mee hoe we hun automatisering compleet kunnen maken. Om de eventueel nog aanwezige handmatige of repeterende zaken verder te digitaliseren én nieuwe opties te integreren binnen het applicatielandschap.”
Bram de Vrught vertelt dat QING op hun stand bezoekers zelf wil laten ervaren hoe je AI op gebruiksvriendelijke wijze inzet. “Zo geven we hen vertrouwen om samen met ons de benodigde innovatiestappen te zetten.
Net zoals wij dat doen met onze lezing op 15 mei: ‘Ik wil Bolletje! Maar wat wil Bolletje nou eigenlijk?’ Een praktijkcase over hoe Bolletje en QING samenwerken om met een beheersbare aanpak nog meer controle over het productieproces te krijgen.”
Staubli lanceert samen met QING op het demoplein een nieuwe robotopstelling met AI-integratie, waarmee het mogelijk is om een product - ongeacht de veranderingen in het product of omgeving - te bewerken of te verplaatsen. Jan Buit: “Over digitalisering vertellen doe ik graag, maar laten zien is sterker. Veel mensen lezen erover, en hikken er tegenaan. Ze kunnen nu in de praktijk beleven wat het inhoudt.”
VOEDINGSINDUSTRIE APRIL 2024 39
©QING, FORWARD ENGINEERING
































































Food Tech Event Brabanthallen: 15 en 16 mei

FENS | HAL 3 STAND 11
DUURZAAM ONDERHOUD: MINDER PRODUCTEN, BETERE PRESTATIES
Bezoek FenS op stand 11 voor een innovatieve reductie in producten via Berusynth H1’s volledig synthetische oliën. Profiteer van minder foutgevoeligheid, lagere onderhoudskosten, en neutraal van geur en smaak. Deze oliën zijn onderling mengbaar, bieden excellente bescherming tegen slijtage en corrosie, en komen met de onderscheidende service van FenS als exclusieve distributeur in de Benelux. FenS biedt ook ondersteuning bij smeerplannen, gratis olie-analyses voor optimale machineprestaties en levert uit voorraad.
SOLARUS SMART ENERGY SOLUTIONS | HAL 3 STAND 189 ZONNEPANELEN MET 89% EFFICIËNTIE
Solarus Smart Energy Solutions introduceert haar revolutionaire zonnepanelen, geoptimaliseerd voor de foodindustrie. “Deze technologie produceert tot 4 keer meer energie dan traditionele panelen, wat resulteert in lagere energiekosten en een snellere terugverdientijd. Daarnaast levert het een aanzienlijke bijdrage aan CO2-reductie, essentieel voor de verduurzaming van de sector.”
“We zijn trots om deze baanbrekende oplossingen te presenteren,” zegt Niels Stolk, CEO van Solarus Smart Energy Solutions. “Ze betekenen een revolutie in de zonneenergiemarkt en helpen de foodindustrie te verduurzamen.” Bezoek onze stand om meer te leren over onze oplossingen.
www.solarus.com


JANSEN TECHNIEK | HAL 3 STAND 151
UW PRODUCTIE NAAR EEN
HOGER NIVEAU?
Bij Jansen Techniek bedenken, ontwerpen, bouwen en onderhouden wij passende oplossingen voor uw productie. Onze Robotische Operator (R-OP) zal u aan het werk zien tijdens het Food Tech Event. R-OP vervangt een operator en is daarmee de oplossing voor repeterend werk. Daarnaast vertellen wij u graag meer over onze transportbanden, weeg- en sorteersystemen, maar ook over onze Fortress metaaldetectoren.
Heeft u een vraag of wilt u een afspraak maken tijdens de beurs? Mail naar info@jansentechniek.nl met uw vraag. Wij denken graag met u mee voor de juiste oplossing!
www.jansentechniek.nl
www.fens.com
VOEDINGSINDUSTRIE APRIL 2024 42


DRT INDUSTRIAL FLOORING | HAL 3 STAND 129
REVOLUTIONAIRE EENDAAGSE VLOERRENOVATIE
APTEAN | HAL 3 STAND 125 INZICHT IN WAT ER WERKELIJK
IN JE FABRIEK GEBEURT
Met Aptean’s foodspecifieke oplossingen stroomlijn en optimaliseer je je productieomgeving, zodat je altijd direct kunt inspelen op veranderende eisen van weten regelgeving en de wensen van de consument. Met de juiste combinatie van software oplossingen zorg je ervoor dat gegevens naadloos tussen afdelingen en processen stromen, zodat je end-to-end inzicht hebt en werkt met één bron van waarheid.
Aptean’s Food & Beverage softwareplatform in de cloud is volledig geïntegreerd en altijd up-to-date, bestaande uit verschillende oplossingen die zijn ontwikkeld voor de unieke uitdagingen van de foodsector: ERP, PLM, OEE, MES, EAM, BI. Kom een kijkje nemen op stand 125 en ontdek wat branchesoftware voor jouw productiebedrijf kan betekenen!
www.aptean.com
DRT Industrial Flooring introduceert een revolutionair eendaags vloerrenovatiesysteem, specifiek voor de foodsector. Dit systeem belooft minimale downtime met behoud van maximale kwaliteit, zonder concessies op chemische resistentie, hygiëne, en antislipklasse. Het systeem speelt in op de behoefte aan snelle, efficiënte renovaties die de operationele voortgang niet onderbreken, terwijl ze voldoen aan de strikte eisen van de voedselverwerkingsindustrie. Ontdek deze innovatie op de Foodtech beurs in ‘s-Hertogenbosch en leer hoe uw bedrijf kan profiteren van snelle en kwalitatieve vloerrenovatie.
www.drt.nl


HAPBV - HYGIËNISCHE AFBOUWPROJECTEN BV | HAL 3 STAND 175
DÉ SPECIALIST IN HYGIËNISCHE
BEDRIJFSRUIMTES
“HAPbv, gespecialiseerd in de afwerking van wanden, plafonds, kozijnen, deuren, vloeren en plinten, richt zich voornamelijk op ruimtes waar strenge hygiëne-eisen gelden (bijvoorbeeld HACCP). Voor renovatie, nieuwbouw of onderhoud bent u bij HAPbv aan het juiste adres. Van voedings- tot farmaceutische industrie, maar ook huisvesting- en zorginstellingen. Met de juiste materialen creërt HAPbv een langdurig kwalitatieve bedrijfsruimte, perfect aansluitend bij uw wensen. Onze oplossingen voldoen aan de hoogste normen op het gebied van hygiëne, zodat u kunt voldoen aan de geldende voorschriften.” www.hapbv.nl
VOEDINGSINDUSTRIE APRIL 2024 43














THEORIE, VALKUILEN EN AANDACHTSPUNTEN
pH METEN IN VOEDING
De pH-waarde is één van meeteenheden waarmee we een voedingsproduct kunnen karakteriseren. Doorgaans wordt deze waarde als eenvoudig te meten eigenschap toegevoegd aan de lijst uit te voeren analyses. Maar vergis je niet: dat kan je duur komen te staan!
De pH is een maat voor de zuurtegraad van een waterige oplossing. Droge stoffen, poeders, puur vet en olie bevatten geen water; hierbij kan dan ook geen pH gemeten worden. Door het meten van de pH krijg je zicht op één of meer eigenschappen van het (eind)product; bijvoorbeeld de structuur, het vermogen tot schuimvorming, de houdbaarheid, kleur en/of smaak. De pH kan variëren van 0 tot 14, waarbij 1 sterk zuur is en 13 hoog alkalisch. Een neutrale oplossing heeft een pH van 7.
door Theo Verkleij en Remco Hamoen, Wageningen Food & Biobased Research STRIPS
Het meten met een strip is gebasseerd op het feit dat de (chemische) verbinding lakmoes rood kleurt in een zure en blauw in een basische oplossing. De pH kan ook vastgesteld worden door een stukje lakmoespapier in de vloeistof te dompelen. De verkleurde strip wordt vergeleken met de bijgeleverde kleurenschaal.
INDICATOREN
De pH wordt uitgedrukt als negatieve logaritme van de concentratie H3O+ ionen in die oplossing. In formulevorm is dit gedefinieerd als

Vaak wordt aangegeven dat pH de concentratie H+ is. Het juiste referentie-ion is het hydronium ion (H3O+), dat zich vormt als

MEETMETHODES
Het meten van de pH kan met strips, een pH-indicator in de oplossing, of met een meetinstrument.
Bij (chemische) processen is het vaak noodzakelijk de pH in de vloeistof te kennen, of wil je deze bijstellen naar een andere waarde. Dit kan door een pH-indicatorvloeistof toe te voegen die binnen een nauwe pH-range van kleur verandert. Deze pH-indicatoren zijn echter niet food grade.
MEETINSTRUMENTEN
Meetinstrumenten om de pH te meten werken allemaal volgens hetzelfde meetprincipe: een sensor (electrode) die gevoelig is voor het waterstof-ion stelt de concentratie hydronium-ionen vast en vergelijkt deze met een referentiesignaal. De meet-electrode geeft een potentiaal op basis van de aanwezige waterstofionen, de referentie electrode geeft een vast potentiaal. Het potentiaalverschil

tussen deze twee is een maat voor de pH van de oplossing.
Goed om te weten is dat de factor temperatuur het potentiaalverschil tussen beide electrodes beïnvloedt. Bij een lage temperatuur neemt de spanning af, bij een hogere temperatuur neemt deze toe. Voor nauwkeurige metingen moet je hiervoor compenseren. Moderne pH-sensoren beschikken doorgaans over een zogenaamde Automatische Temperatuur Compensatie (ATC).
Wetenschap
VOEDINGSINDUSTRIE APRIL 2024 46

Er zijn verschillende typen pH-sensoren. Zo zijn er sensoren met een puntvormige tip om in ‘vaste stoffen’ te meten en sensoren waarbij er een mes voor de tip is geplaatst zodat bijvoorbeeld vlees eerst kan worden ingesneden.
EEN CORRECTE METING
Vervuiling op de sensor kan de meting flink
verstoren. pH-meters geven ondanks vervuiling wel een waarde aan. Het is goed om je te realiseren dat deze waarde veelal niet correct is. Reinigen van de electrode mag alleen gebeuren met een speciale reinigingsvloeistof. Dit om te voorkomen dat de gevoelige membraan beschadigt.
Kalibreren van de pH-meter doe je met bufferoplossingen. Vaak is een tweepunts kalibratie
voldoende. Dan kan je volstaan met een bufferoplossing in het zure traject (pH 4) en in het neutrale traject (pH 7). Soms wordt een driepuntskalibratie uitgevoerd, waarbij een meting in een alkalische buffer (pH 10) wordt toegevoegd. Kalibratie moet minimaal elke dag (voorafgaand aan de meting) worden uitgevoerd.
AANDACHTSPUNTEN BIJ HET METEN VAN PH Het meten van de pH van sappen is een vrij
>>
VOEDINGSINDUSTRIE APRIL 2024 47









































































































 door Saskia Stender
door Saskia Stender

















































































 ©TON KASTERMANS
©TON KASTERMANS